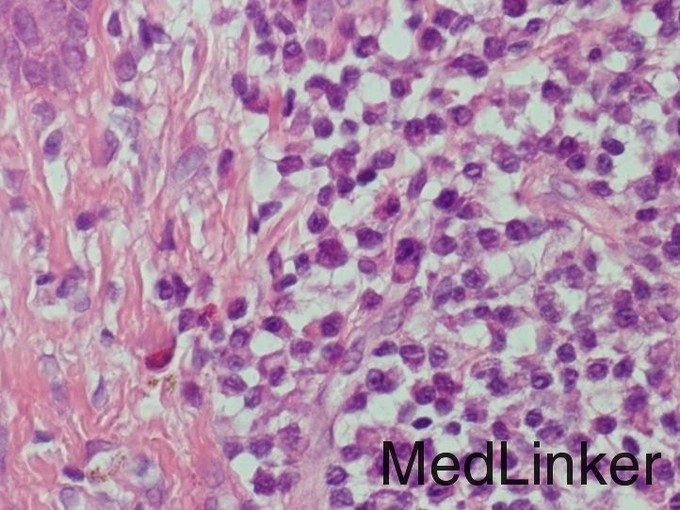

下载或打开 医联APP 查看完整评论
立即下载
打开APP
皮肤假性淋巴瘤一例
主诉 病史
患者 41 岁男性,患肥厚融合性斑块型银屑病,曾后接受窄波 UVB 光疗、2 次 PUVA 治疗但疗效不佳,遂更换环孢素 4 mg/kg·d 治疗。 患者接受环孢霉素治疗后 2 个月内,曾出现一过性中性粒细胞减少、踝关节水肿和盗汗,胸片和结核菌素试验未见异常。 治疗 10 个月后,患者下背部出现了蓝黑色皮肤结节(见图 1)。
查体 辅查
组织病理学检查显示淋巴细胞和浆细胞为主的皮肤浸润(见图 2)。浆细胞群 κ 和 λ 链染色显示比率正常,诊断皮肤假性淋巴瘤,倾向于反应性。梅毒血清学和 T 细胞受体基因重排检查阴性。

诊断 处理
诊断:皮肤假性淋巴瘤 治疗:患者结节在 4 周内增多、变大,同时伴高血压和肌酐升高,遂降低环孢霉素剂量后停药,同时加用阿维 A。在环孢霉素停药 4 天内,结节数量和大小均减少。3 个月后完全消退。患者接受了阿达木单抗 40 mg/w 维持治疗,2 年内结节未复发。
随访 讨论
皮肤假性淋巴瘤为一组在临床和组织学上模仿皮肤淋巴瘤的异质性疾病,是不同原因所致的 T 细胞或 B 细胞良性反应性增殖。还不清楚皮肤假性淋巴瘤是否会进展为淋巴瘤。 尽管大多数病例为特发的,也有人报告皮肤假性淋巴瘤与纹身、疫苗接种、感染和炎症性皮病相关。药物诱发的皮肤假性淋巴瘤最常见于抗癫痫药(苯妥英、卡马西平、拉莫三嗪、丙戊酸钠),但使用 TNF 拮抗剂、甲氨蝶呤、钙通道阻滞剂和他莫昔芬时也有报告。 在大多数病例中,停药后皮损消退。在本病例中,环孢霉素停药与结节迅速消退的结局提示与环孢霉素有关。 doi: 10.1016/j.jaad.2014.09.008.
发布于 15-10-31 21:42
